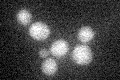
YJR021C
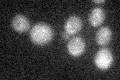
YJR021C

View description
Protein involved in early stages of meiotic recombination; involved in coordination between the initiation of recombination and the first division of meiosis; part of a complex (Rec107p-Mei4p-Rec114p) required for ds break formation
Localization:
Intensity:
Fold change:
Significance:
-
C’ GFP library in SD
below threshold14.36 -
N' NOP1pr-GFP in SD

N/A0 -
N' TEF2pr-mCherry in SD

N/A0 -
N' NATIVEpr-GFP in SD

N/A0 -
N' TEF2pr-VC and Cyto-VN in SD

N/A0 -
C’ GFP library in SD+DTT

cytosol15.791.09No -
C’ GFP library in SD+H2O2
cytosol18.891.31No -
C’ GFP library in Starvation Media

cytosol21.31.48No -
C’ GFP library on the background of Pup2-DaMP

below threshold -
C’ GFP library on the background of CCT mutant

below threshold16.2981.13444No
